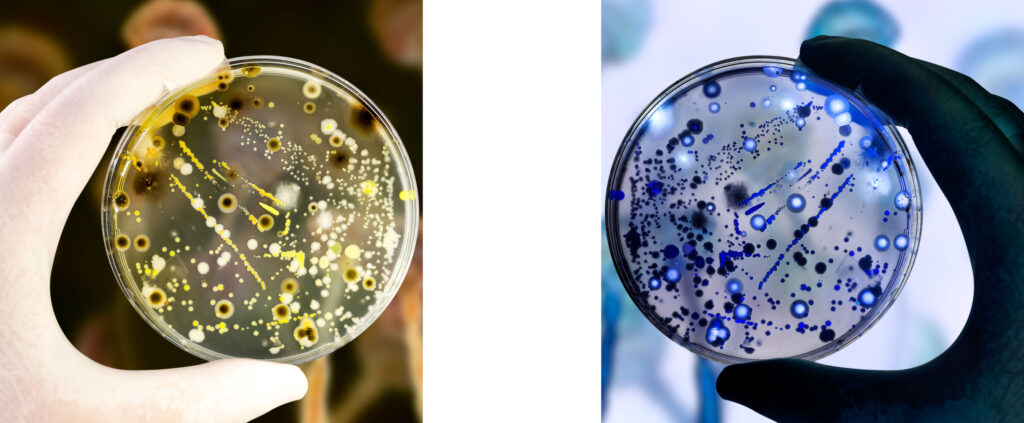

The Download: NASA’s nuclear spacecraft and unveiling our AI 10
This is today’s edition of The Download, our weekday newsletter that provides a daily dose of what’s going on in the world of technology. NASA is building the first nuclear reactor-powered interplanetary spacecraft. How will it work? Just before Artemis II began its historic slingshot around the moon, NASA revealed an even grander space travel plan. By the end of 2028, the agency aims to fly a nuclear reactor-powered interplanetary spacecraft to Mars. A successful mission would herald a new era in spaceflight—and might just give the US the edge in the race against China. But the project remains shrouded in mystery. MIT Technology Review picked the brains of nuclear power and propulsion experts to find out how the nuclear-powered spacecraft might work. Here’s what we discovered. —Robin George Andrews This story is part of MIT Technology Review Explains, our series untangling the complex, messy world of technology to help you understand what’s coming next. You can read more from the series here. Coming soon: our 10 Things That Matter in AI Right Now Each year, we compile our 10 Breakthrough Technologies list, featuring our educated predictions for which technologies will change the world. Our 2026 list, however, was harder to wrangle than normal. Why? We had so many worthy AI candidates we couldn’t fit them all in! That got us thinking: what if we made an entirely new list all about AI? Before we knew it, we had the beginnings of what we’re calling 10 Things That Matter in AI Right Now. On April 21, we’ll unveil the list on stage at our signature AI conference, EmTech AI, and then publish it online later that day. If you want to be among the first to see it, join us at EmTech AI or become a subscriber to livestream the announcement. Find out more about the list’s methodology and aims here. —Niall Firth & Amy Nordrum MIT Technology Review Narrated: this company is developing gene therapies for muscle growth, erectile dysfunction, and “radical longevity” In January, a handful of volunteers were injected with two experimental gene therapies as part of an unusual clinical trial. Its long-term goal? To achieve radical human life extension. The therapies are designed to support muscle growth. The company behind them, Unlimited Bio, also plans to trial similar therapies in the scalp (for baldness) and penis (for erectile dysfunction). But some experts are concerned about the plans. Find out why the trial has divided opinion. —Jessica Hamzelou This is our latest story to be turned into an MIT Technology Review Narrated podcast, which we publish each week on Spotify and Apple Podcasts. Just navigate to MIT Technology Review Narrated on either platform, and follow us to get all our new content as it’s released. The must-reads I’ve combed the internet to find you today’s most fun/important/scary/fascinating stories about technology. 1 Google, Microsoft, and Meta track users even when they opt out According to an independent audit, they may be racking up billions in fines. (404 Media) + How our digital devices put our privacy at risk. (Ars Technica) + Privacy’s next frontier is AI “memories.” (MIT Technology Review) 2 OpenAI has a new cybersecurity model—and strategy GPT-5.4-Cyber is designed specifically for defensive cybersecurity work. (Reuters $) + OpenAI has joined Anthropic in focusing on cybersecurity recently. (Wired $) + Like Anthopic, its latest model is only available to verified testers. (NYT $) + AI is already making online crimes easier. It could get much worse. (MIT Technology Review) 3 Amazon is buying satellite firm Globalstar in a bid to rival Starlink The $11.6 billion deal targets the lucrative satellite internet market. (WSJ $) + Apple has chosen Amazon satellites for iPhone. (Ars Technica) 4 What it’s like to live with an experimental brain implant Early BCI users explain what the technology gives—and takes. (IEEE) + A patient with Neuralink got a boost from generative AI. (MIT Technology Review) 5 Dozens of AI disease-prediction models were trained on dubious data A few might already have been used on patients. (Nature) 6 Uber is breaking from its gig economy model to avoid robotaxi disruption It’s spending $10 billion to buy thousands of autonomous vehicles. (FT $) 7 xAI is being sued over data center pollution Musk’s AI venture stands accused by the NAACP of violating the Clean Air Act. (Engadget) + No one wants a data center in their backyard. (MIT Technology Review) 8 Apple could win the AI race without running It may reap the rewards of everyone else’s spending. (Axios) 9 How 4chan set a precedent for AI’s reasoning abilities The notorious forum tested a feature called “chain of thought.” (The Atlantic $) 10 The surprising emotional toll of wearing Meta’s AI sunglasses Their shortcomings are making users sad. (NYT $) Quote of the day “Everything got a whole lot worse once they rolled out AI.” —A copywriter tells the Guardian that they’re drowning in “workslop” — AI-generated work that seems polished but has major flaws One More Thing GETTY IMAGES How refrigeration ruined fresh food Bananas may not be chilled in the grocery store, but they’re the ultimate refrigerated fruit. It’s only thanks to a network of thermal control that they’ve become a global commodity. And that salad bag on the shelf? It’s not just a bag but a highly engineered respiratory apparatus. According to Nicola Twilley—a contributor to the New Yorker and cohost of the podcast Gastropod—refrigeration has wrecked our food system. Thankfully, there are promising alternative preservation methods. Read the full story on her research. —Allison Arieff We can still have nice things A place for comfort, fun and distraction to brighten up your day. (Got any ideas? Drop me a line.) + Spotify only shows 10 popular songs per artist. This tool lists them all. + These GIF animations are mesmerizing loops of nostalgia. + This site beautifully visualizes Curiosity’s 13 years on Mars. + A retro-futurist designer has turned a NES console into a working synthesizer.
The Download: NASA’s nuclear spacecraft and unveiling our AI 10 Beitrag lesen »